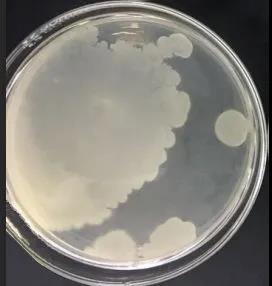
圖片
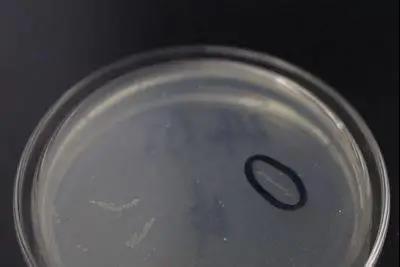
圖片

今天,小編就和大家說說菌落總數檢測中常見的一些問題。
一、菌落總數知識
1、食品中測定的菌落總數就是食品的細菌總數嗎?
不是的,菌落總數是指在一定條件下(如需氧情況、營養條件、PH等)每克(每毫升)檢樣所生長出來的細菌菌落總數。
按國家標準方法規定,即在需氧情況下,36±1℃培養48±2h,能在平板計數瓊脂平板上生長的細菌菌落總數,因此,厭氧或微需氧菌等,由于現有條件不能滿足其需求,故難以繁殖生長。
2、菌落總數的單位CFU和“個”有區別嗎?
菌落形成單位叫做CFU。CFU是形成菌落的個數,不等于細菌個數。比如兩個相同的細菌靠的很近或粘在一起,那么經過培養這兩個細菌將會形成一個菌落,此時就是2個細菌,1CFU。
3、菌落總數超標會導致食物中毒嗎?
不一定,菌落總數測定是用來判斷食品被細菌污染的程度及衛生質量,反應食品在生產過程中是否符合衛生要求,以便被檢樣品做出適當的衛生學評價。

4、菌落總數超標如何追溯?
在日常抽檢中發現產品菌落總數超標,可以從以下三個環節進行追溯:
(1)生產環節
如果在不合格食品同批次庫存產品多次抽樣檢驗,均出現菌落總數超標的情況,那極有可能是生產環節原輔料、人員、設備環境等受污染所影響;
(2)儲存運輸
對同批次其他產品進行多次抽樣檢驗,均未檢出菌落總數超標的現象,那么有可是出現在產品裝卸搬運過程中;
(3)儲存擺放環節
若在流通環節檢出多種食品存在菌落總數超標的情況,則問題極有可能是未按照規定要求存儲、擺放食品,致使微生物滋生。
二、實驗過程中的問題
1、為什么平板計數瓊脂需要調節pH?
培養基的酸堿度應符合細菌生長要求。平板計數瓊脂是用來檢測樣品中的菌落總數的,而大部分細菌都是嗜中性的,所以需要調節培養基pH至7.0±0.2,保證細菌生長環境的適宜,從而確保檢測結果的準確性。
2、為什么菌落總數培養條件為36±1℃培養48±2h,而水產品要求30±1℃培養72±3h?
對于未經過任何加工的水產品,其菌落總數培養條件為30±1℃培養72±3h;
因為水中本身溫度較低,未加工的水產品中微生物主要來源于水體,30℃、72h是水中微生物最適培養溫度和時間。而加工水產品和其他產品培養條件都是36±1℃培養48±2h,其實就是產品本身的菌和加工過程中帶入的菌的最適培養溫度和時間不同的問題。

3、如何保證檢測結果的有效性?
檢驗過程中需要做空白對照,用來判斷培養基、稀釋液、平皿或吸管是否存在污染。并做好定期檢測空氣潔凈度,判斷實驗環境是否符合標準要求。
三、菌落計數小問題
1、菌落蔓延的原因及解決辦法?
菌落蔓延主要有兩個原因,一是操作不當;二是樣品中含有變形桿菌等運動性強的細菌。
操作中需要注意3個關鍵點:
(1)傾注培養基時搖晃平皿使其混合均勻,減少菌塊;
(2)樣品稀釋后,盡快傾注平板。從稀釋到傾注結束時間控制在30 分鐘之內,避免樣液干涸造成菌落成團;平板凝固后馬上倒置。

(3)若樣品中含有變形桿菌,則可以覆蓋一層培養基。
2、如何區分細菌菌落與食品顆粒?
如果平板上食品顆粒與菌落形態較為接近,為避免和細菌菌落發生混淆,可多傾注一塊平板置于4℃冰箱中放置,在計數時用于對照。另外也可以在已融化而保溫在46℃水浴的PCA中加入0.5%TTC溶液,培養后食品顆粒不變色,細菌為紅色。注意TTC的濃度不要過高,會有抑制細菌生長作用(食品檢測一般不建議使用TTC,會有一定的抑菌效果)。
3、異常現象平板如何進行菌落計數?
我們通過以下表格查看:

菌落總數是評價食品衛生質量的重要指標,其檢測工作在某種程度上具有相當的不可比性,這就要求檢測人員要嚴格執行科學的操作程序,保證科學、準確地得出符合樣品實際的檢測結果。








當前所在頁面:















